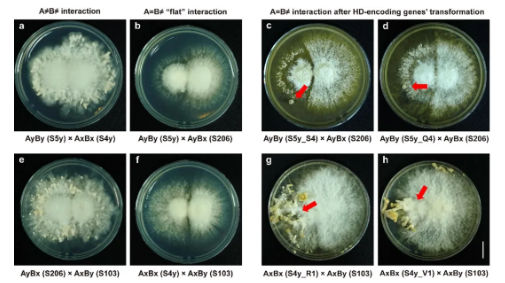
世界杯投注平台

研究背景
裂褶菌 (Schizophyllum commune) 是一种重要的药食两用真菌,也是研究真菌遗传与发育的经典模型。其有性生殖由A、B两个交配型位点共同调控。在A位点,Aα与Aβ两个亚位点紧密关联。已有研究发现,Aα亚位点通过同源结构域蛋白Y (HD2) 与Z (HD1) 之间的“非自身识别”作用,形成异源二聚体,从而启动真菌的发育过程。然而,Aβ亚位点编码的蛋白及其互作机制仍不明晰,尤其是它在性相容性和发育中的作用。这一知识空白限制了我们对裂褶菌有性生殖全局调控机制的理解,也影响了其在菌种选育中的应用。
近期,世界杯投注平台生命科学学院刘常宏教授团队在 Journal of Fungi 期刊上发表了一项研究,深入解析了裂褶菌Aβ亚位点的HD蛋白组成与功能,揭示了这些蛋白在性相容性与子实体发育中的关键作用,为真菌有性生殖机制的研究与菌种选育提供了新的理论基础。
研究方法与结果
(1) 关键蛋白的发现:通过基因组测序与注释,团队鉴定出了Aβ亚位点的4个HD基因:abr、abs、abv 和abq,编码两种HD1蛋白 (S和Q) 和两种HD2蛋白 (R和V)。这些蛋白以“头对头”方式成对排列。

图1. S. commune 20R-7-F01菌株中A交配型位点的结构与系统发育
(2) 蛋白互作的锁定:通过蛋白质结构互作预测、双分子荧光互补 (BiFC) 与Pull-down实验,研究发现R-S与V-Q这两组蛋白能够特异性地发生相互作用,而其他组合 (如R-Q、V-S) 则无法互作。

图2. 裂褶菌中HD蛋白的蛋白质结构互作预测、BiFC和Pull-down互作验证
(3) 体内功能验证:研究人员在A交配型位点相同而无法产生子实体的“不育”菌株中引入“异己”蛋白 (如在携带R1-S1的菌株中引入S4蛋白),使这些菌株奇迹般地产生了子实体原基和子实体,证明了R-S与V-Q的相互作用是启动裂褶菌有性生殖与子实体发育的关键。
图3. 裂褶菌中HD互作蛋白的体内功能验证
研究总结
本研究首次揭示了裂褶菌Aβ交配型亚位点的分子机制。该位点通过R-S与V-Q这两对特定的HD1-HD2蛋白进行“非自身识别”配对,形成异源二聚体,启动A交配型位点的有性生殖通路。这表明,裂褶菌的A交配型位点比我们以往的认识更加复杂精密,Aα与Aβ两个亚位点可独立调控裂褶菌的性相容性和子实体发育,从而确保遗传识别的准确性与后代的多样性。
该研究不仅深化了我们对真菌有性生殖机制的理解,还为通过分子标记辅助育种与基因编辑技术选育优良食药用真菌品种提供了坚实的理论基础和技术路径。